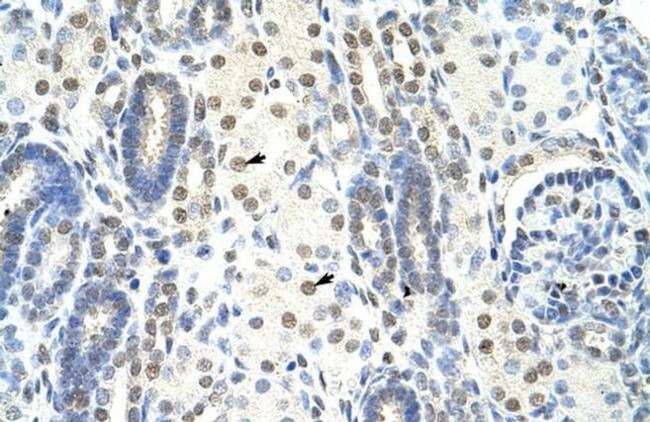
SF1 Antibody in Immunohistochemistry (Paraffin) (IHC (P))

Search
Invitrogen
SF1 Polyclonal Antibody
{{$productOrderCtrl.translations['antibody.pdp.commerceCard.promotion.promotions']}}
{{$productOrderCtrl.translations['antibody.pdp.commerceCard.promotion.viewpromo']}}
{{$productOrderCtrl.translations['antibody.pdp.commerceCard.promotion.promocode']}}: {{promo.promoCode}} {{promo.promoTitle}} {{promo.promoDescription}}. {{$productOrderCtrl.translations['antibody.pdp.commerceCard.promotion.learnmore']}}



Please note: We are reviewing Western blot images included in the antibody testing data in our catalog, including those provided by third parties. Unless expressly labeled or annotated as “raw-unedited”, Western blot images included in the antibody testing data in our catalog may have been edited, optimized or otherwise adjusted for presentation.
产品信息
PA5-41967
种属反应
已发表种属
宿主/亚型
分类
类型
抗原
偶联物
形式
浓度
规格
纯化类型
保存液
内含物
保存条件
运输条件
RRID
产品详细信息
Peptide sequence: NATPLDFPSK KRKRSRWNQD TMEQKTVIPG MPTVIPPGLT REQERAYIVQ
Sequence homology: Cow: 100%; Dog: 100%; Guinea Pig: 100%; Horse: 100%; Human: 100%; Mouse: 100%; Rabbit: 100%; Rat: 100%; Zebrafish: 86%
靶标信息
Splicing factor 1 is a nuclear pre-mRNA splicing factor. The protein specifically recognizes the intron branch point sequence at the 3' splice site, together with the large subunit of U2 auxiliary factor (U2AF), and is required for the early stages of spliceosome assembly. It also plays a role in nuclear pre-mRNA retention and transcriptional repression. The protein contains an N-terminal U2AF ligand motif, a central hnRNP K homology motif and quaking 2 region which bind a key branch-site adenosine within the branch point sequence, a zinc knuckles domain, and a C-terminal proline-rich domain. Alternative splicing results in multiple transcript variants.
仅用于科研。不用于诊断过程。未经明确授权不得转售。
生物信息学
蛋白别名: BBP; branch point-binding protein; M ZFM1; Mammalian branch point-binding protein; SF; Splicing factor 1; Transcription factor ZFM1; unnamed protein product; Zinc finger gene in MEN1 locus; Zinc finger protein 162
基因别名: BBP; D11S636; MBBP; SF1; ZCCHC25; ZFM1; ZNF162
Entrez Gene ID: (Human) 7536